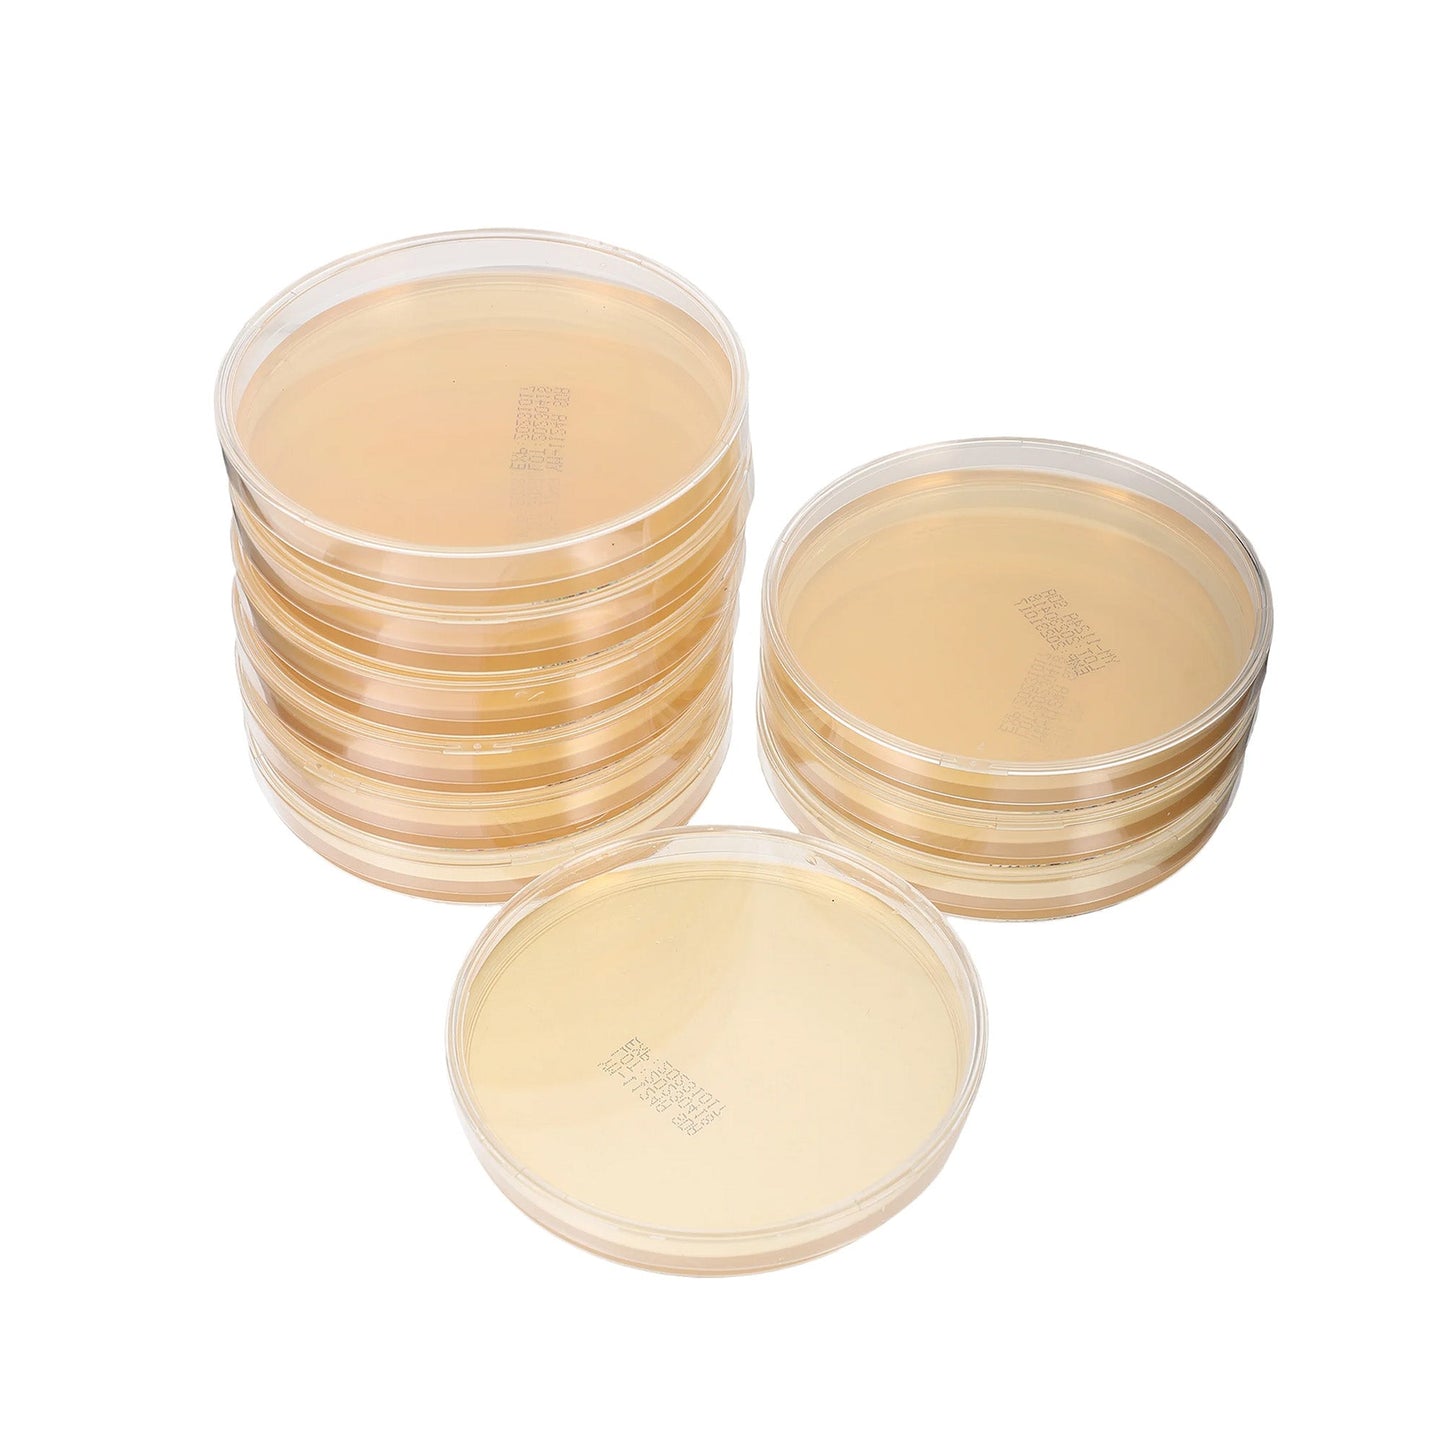
Paquete de 10 placas de Petri pre-vertidas

Paquete de 10 placas de Petri pre-vertidas
Paquete de 10 placas de Petri pre-vertidas
Precio habitual
£16.99 GBP
Precio habitual
Precio de oferta
£16.99 GBP
Precio unitario
/
por
Impuestos incluidos.
Los gastos de envío se calculan en la pantalla de pago.
Información adicional
Información adicional
- Envío rápido
- Devoluciones en 30 días
- Productos de alta calidad
- Descuento de membresía
No se pudo cargar la disponibilidad de retiro